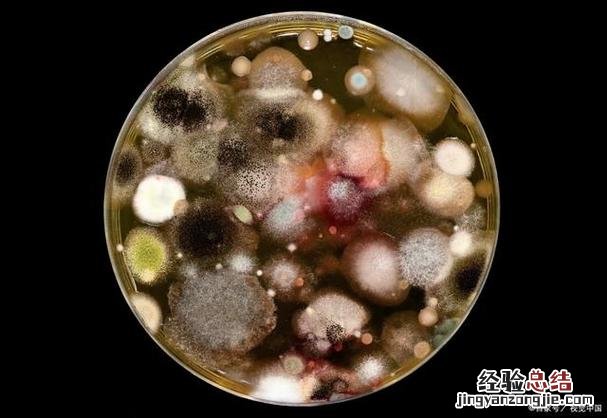

从生物的概念看,“生物”一词最初于1863年由法国生物学家维克多·达尔文在其著作《物种起源》中提出,后来于1895年被美国生物学家莫尔斯在其著作《细胞》中再次提出并沿用至今 。“生物”一词在不同语言中有不同的解释,但都认为生物是一种生物现象或生物存在的形式 。细菌、真菌、细菌分属不同的生命范畴;病毒、昆虫和病毒等生物体有自己的生命形式;病毒和细胞等生物体是一种非生物的生命现象;昆虫有自己的“生命细胞”(有节肢动物细胞、放线菌细胞等)和“细胞工厂”(有细胞)等生物体形式;生物体则是一种独立于生命形式之外的存在状态 。由于细菌和生物存在方式的不同,使我们无法准确地将细菌和生物区分开来.因为细菌与生物之间存在着相互独立、相互联系的两种关系 。细菌有哪些特征?
1.不能自行繁殖 。
细菌具有自我繁殖、自我更新的能力,能在几秒钟内繁殖几十个甚至上百个菌种(有的种类甚至能多达几百个菌种),其繁殖能力在自然界中是十分罕见的 。同时,作为一种高度适应环境的生命体,细菌本身也不可能自行繁殖 。首先因为细菌是一种无生命组织,它是无细胞状态 。只有它的细胞才具有分裂、生长等多种生命活动,也只有当它分裂成若干个单细胞时才有繁殖、生长等一系列新陈代谢活动;其次因为细菌具有自我更新能力,能利用环境条件自动完成繁殖、生长、代谢等活动 。例如:在某些条件下(如 pH值、水分充足),细菌可以把自己看成是一种能够产生大量养料的食物,把营养物质分解为氨基酸、葡萄糖和其它无机盐等物质通过分裂繁殖生产出大量新菌 。
2.有生命力 。
从分子生物学的角度看,细菌是一种有生命力的生命形式 。因为无论它长得多么大、多么强壮,它都具有自我保护的能力,即在外部环境很容易被其他微生物所感染 。细菌还具有很强的生命力 。在自然界中,许多细菌是寄生在植物和动物体内,而不是寄生在动物体内 。细菌还有一些特殊的生长方式——固氮 。细菌是一种氮气循环系统 。当水中的氮离子含量超过细菌体内必需氮气的含量时,细菌会大量消耗氮气 。
3.与环境有一定的联系 。
【细菌属于生物吗】
在自然条件下,土壤中的微生物数量和质量非常丰富,而在人工合成和培植条件下,微生物数量及质量都大幅度下降 。在人工合成的环境中,微生物大多是自养的,而许多微生物是完全依赖于外界条件而生长和繁殖的 。自然界中能利用有机物质并能产生能量的微生物共有约40多种 。这些微生物是人类社会发展以来才出现的新物种 。它们或从自然界直接获得所需的营养物质、或从外界获得环境中可以获得的各种物质和能量、或从自然界获得或从土壤、空气、水中获得生长所需的物质或能量 。细菌生长和繁殖与周围环境有关 。
